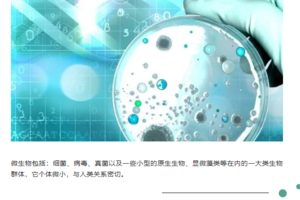

¥{{el.discountedPrice}}
会员专享
新用户专享
普通用户专享
所有用户可用
无门槛限制
满{{el.fullAmount}}元使用
截至{{el.fixedDate|date('yyyy-MM-dd HH:mm')}}
领取之日{{el.expiredDays}}天内有效
立即领取
已领取